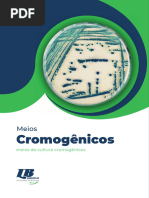

0% acharam este documento útil (0 voto)
210 visualizações8 páginasAgar Cromogênico PDF
O documento descreve um estudo que avaliou a utilização de meios cromogênicos para identificação de uropatógenos em amostras de urina. Foram analisadas 1.409 amostras de urina utilizando um meio cromogênico, das quais 220 foram positivas. Os principais uropatógenos identificados foram Escherichia coli (62,7% das amostras positivas) e Proteus mirabilis. A identificação direta pelo meio cromogênico foi confirmada bioquimicamente em 99,3
Enviado por
De Conto ContatosDireitos autorais
© © All Rights Reserved
Levamos muito a sério os direitos de conteúdo. Se você suspeita que este conteúdo é seu, reivindique-o aqui.
Formatos disponíveis
Baixe no formato PDF, TXT ou leia on-line no Scribd
0% acharam este documento útil (0 voto)
210 visualizações8 páginasAgar Cromogênico PDF
O documento descreve um estudo que avaliou a utilização de meios cromogênicos para identificação de uropatógenos em amostras de urina. Foram analisadas 1.409 amostras de urina utilizando um meio cromogênico, das quais 220 foram positivas. Os principais uropatógenos identificados foram Escherichia coli (62,7% das amostras positivas) e Proteus mirabilis. A identificação direta pelo meio cromogênico foi confirmada bioquimicamente em 99,3
Enviado por
De Conto ContatosDireitos autorais
© © All Rights Reserved
Levamos muito a sério os direitos de conteúdo. Se você suspeita que este conteúdo é seu, reivindique-o aqui.
Formatos disponíveis
Baixe no formato PDF, TXT ou leia on-line no Scribd